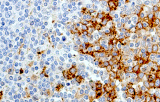
CD138
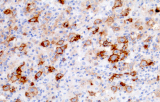
CD25

La inmunohistoquímica (IHC) sigue siendo un método fundamental en hematopatología porque los fenotipos diagnósticamente relevantes pueden resolverse directamente en la arquitectura tisular, utilizando marcadores de linaje, diferenciación y proliferación definidos por anticuerpos. Para cualquier anticuerpo CE-IVD o anticuerpo IHC destinado a flujos de trabajo de investigación clínica/diagnóstica, la práctica basada en evidencia enfatiza la validación analítica y el control de variables preanalíticas y analíticas para garantizar resultados precisos y reproducibles.
¿Qué anticuerpos CE-IVD para IHC en hematopatología se utilizan para interrogar
- Asignación de linaje y principales diagnósticos diferenciales: Fenotipado de células B vs células T (p. ej., CD20 vs CD3), apoyado por factores de transcripción nuclear de células B como PAX5 cuando los marcadores pan-B son débiles o ausentes.
- Paneles orientados a entidades para neoplasias linfoides:
- Linfoma folicular: patrones de coexpresión típicos (p. ej., CD10 con BCL2 aberrante).
- LLC/LLS: coexpresión característica de CD5 y CD23 en células B CD20+, (la interpretación requiere conciencia del patrón porque hay células T reactivas presentes).
- Linfoma de células del manto: ciclina D1 y SOX11 como marcadores clave, incluyendo soporte para casos ciclina D1 negativos.
- Linfoma de Hodgkin clásico: las células tumorales son típicamente CD30+ y a menudo CD15+, con PAX5 débil y CD20 negativo en las grandes células tumorales.